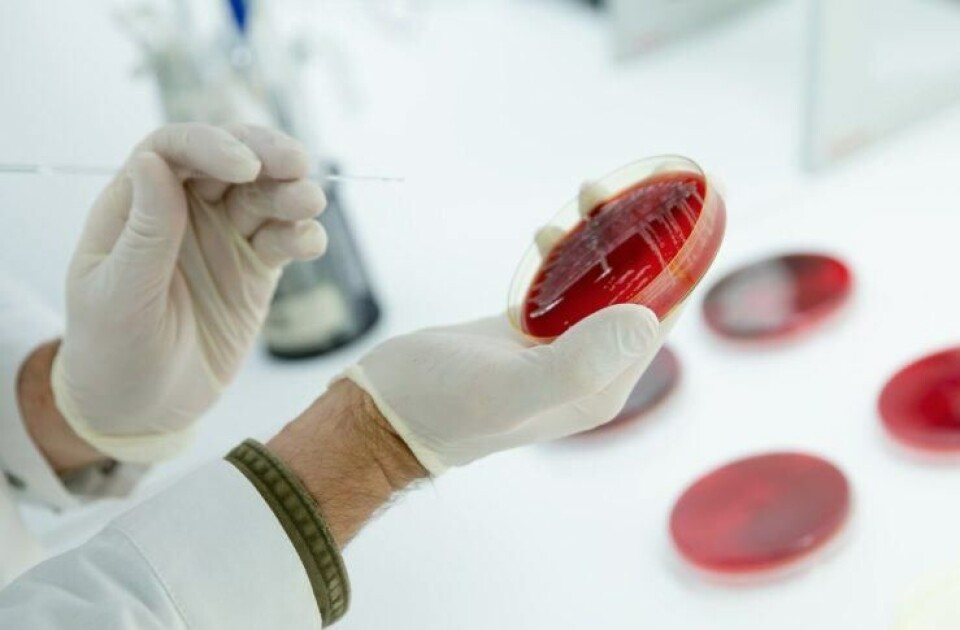
Vaxxinova har kompetanse innen bakteriologi, virologi, serologi og molekylærbiologi. Diagnostikk illustrasjon. Foto: Vaxxinova.

Vaxxinova havnet på minussiden
Legemiddelselskapet Vaxxinova Norway havnet på minussiden med driftsresultatet i år også, selv om de økte både omsetningen og resultatet fra i fjor.
Denne artikkelen er tre år eller eldre.
Omsetningen til selskapet var 12,4 millioner kroner i 2016, sett mot 6,2 millioner året før. Driftsresultatet til legemiddelselskapet økte, men endte likevel på minussiden med - 3,7 millioner i fjor, sett mot - 9,6 millioner i 2015.

Styret skriver i årsberetningen at det fremlagte årsregnskapet viser et underskudd før skatt på omlag minus fire millioner kroner.
Selskapet har finansiert driften gjennom egenkapital og langsiktige lån fra Vaxxinova Gmbh. Gjennom dette er selskapet sikret finansiering på lang sikt.
Selskapets virksomhet er forskning, utvikling, salg markedsføring og teknisk støtte relatert tl vetereinærmedisinske produkter og tjenester. Da spesielt biologiske produkter for akvakulturindustrien samt deltagelse i annen foreningsvirksomhet.
Les også: Ulven har kommet «hem» igjen
Daglig leder Dag Knappskog i Vaxxinova, har tidligere denne måneden uttalt til kyst.no at han synes det er en milepæl for norsk oppdrettsnæring at en DNA vaksine som Clynav, har «gått gjennom møllen». Les saken her.
Vaxxinova holder til på Marineholmen, nært både Universitetet i Bergen og Industrilaboratoriet (Ilab). Plasseringen er ikke tilfeldig, for en stor del av selskapets ressurser brukes på forskning og utvikling og de fleste ansatte har studert bare et steinkast unna.
I 2010 var det ett menneske ansatt i Vaxxinova i Norge, og nå teller selskapet 18 ansatte. Les mer om dette her.
Om selskapet:
- Vaxxinova Norway AS er et legemiddelselskap som ble etablert i 2010 med hovedkontor i Bergen.
- Selskapet utvikler og produserer autogene vaksiner mot bakterie- og virussykdommer hos fisk og husdyr, og jobber tett med havbruksnæringen langs hele norskekysten og internasjonalt.
- Deres ansatte har lang fartstid innen forskning og utvikling samt produksjon og oppfølging av vaksiner.
- Vaxxinova Norway er en del av Vaxxinova-konsernet som har hovedkontor i Nederland og regionkontorer i Tyskland, Japan, Italia og Norge.